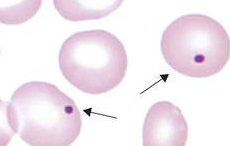
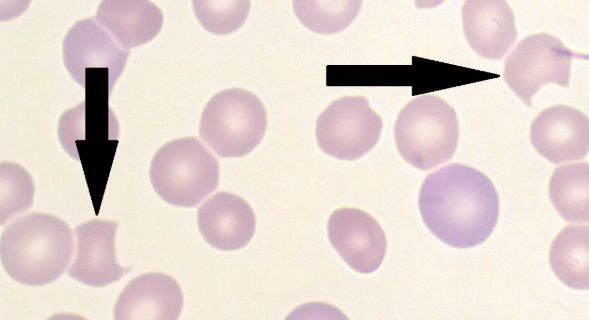

1/72
Looks like no tags are added yet.
Name | Mastery | Learn | Test | Matching | Spaced | Call with Kai |
|---|
No study sessions yet.
Erythrocyte Biconcavity
Contributes to transporting gasses, flexibility, and deformability of the RBC
Discocyte
Other term for biconcave RBC shape
Hemoglobin
A tetramer that contributes to the color and central pallor size of the RBC
Salmon Pink
Normal color of an RBC due to Hgb
5 Million
Average number of circulating RBCs (per uL) of blood
Complex of Heme
4 protoporphyrin IX molecules
4 ferrous iron
4
How many Oxygen molecules can a Hgb molecule carry?
ATP
Slows the oxidation of proteins and iron by environmental peroxides and superoxide anions
Maintains Hgb function and membrane integrity
120 days (± 20 days)
Life span of RBC
Old / Senescent RBCs
Engulfed by MACROs in the spleen
Severely Damaged RBCs
Engulfed by Macros in the liver
Reusable Components of RBC
From Hemoglobin:
globin chains
iron
From Cell Membrane:
phospholipids
proteins
Protoporphyrin Ring
A component in Hgb that isn’t reusable and is excreted as bilirubin
Anaerobic Glycolysis
Due to the lack of mitochondria in an RBC, it relies on this process for energy production (ATP)
Hypoxia
Low levels of oxygen in tissues that stimulates EPO production
Embden-Meyerhof Pathway
Main metabolic pathway of RBCs that undergo anaerobic glycolysis to produce ATP

90 - 95%
Amount of ATP produced by EMP
2
How many net ATP is produced in EMP
ATP Deficiency
Results in
premature cell death due to inherited defects in glycolysis
loss of viability during storage of blood for transfusion
loss of flexibility
deformity
Pyruvate Kinase Deficiency
Results in the formation of echinocytes due to decreased ATP
Burr Cells
Other term for echinocytes; due to an accumulation of lipids in the outer half of the red blood cell's membrane

True
True/False: The iron in our blood needs to be in the ferrous state to be functional
False
True/False: The iron in our blood needs to be in the ferric state to be functional
Hexose Monophosphate Shunt Pathway (HMP)
An alternative pathway that undergoes aerobic / oxidative glycolysis

5 - 10%
Amount of ATP produced by HMP
Pentose Phosphate Shunt (PPS)
Other term for HMP
Glucose-6-Phosphate Dehydrogenase (G6PD)
The enzyme reactant of HMP to produce ATP
Ribulose-5-Phosphate
A product of HMP that is required for the synthesis of RNA
Reduced Nicotinamide Adenine Dinucleotide Phosphate (NADPH)
A product of HMP that reduces oxidized glutathione (GSSG) to produce reduced glutathione (GSH)
Reduced Glutathione (GSH)
A product of HMP that prevents the oxidation of Hgb to MetHgb by maintaining the RBCs ferrous state
Glutathione Reductase
Enzyme required to reduce GSSG
G6PD Deficiency
Most common inherited RBC enzyme deficiency worldwide, leads to deficiency in:
NADPH
GSH
Oxidative Damage
A deficiency in G6PD makes RBCs vulnerable to _____ and will cause Hgb oxidation (Hgb > MetHgb)
Oxidized / Denatured Hgb
Leads to formation RBC inclusions in the cytoplasm
Heinz Bodies
RBC inclusion that is formed due to the Hgb being oxidized
Degmacyte / Bite Cell / Bronze Cell
The result in the removal of Heinz bodies in the RBC cytoplasm, causing a pitted golf ball appearance
Methemoglobin (MetHgb)
The affected Hgb is called as ____ when the iron is in the ferric state
65%
Methemoglobin-reducing capacity of MRP
Cytochrome-b5-Reductase
Other term for MetHgb reductase
Methemoglobin Reductase Pathway
A EMP shunt that reduces ferric iron back to ferrous iron

Rapoport-Luebering Pathway
Produces 2,3-biphosphoglycerate to lower Hgb’s affinity to oxygen (tense state), helping RBCs release oxygen more easily to tissues that need it (in case of hypoxia)

Acidic
pH environment that inhibits the activity of biphosphoglycerate mutase
Right shift
The direction of the hemoglobin-oxygen dissociation curve when Hgb has low affinity to oxygen
8%
Percentage of carbohydrates in RBC membrane
52%
Percentage of proteins in RBC membrane
40%
Percentage of lipids in RBC membrane (equal parts of phospholipids and cholesterol, glycolipids)
RBC Membrane Cholesterol
Contributes to the tensile strength of the lipid bilayer of the RBC
Acanthocytosis
Indicates underlying lipid membrane defects in RBCs
RBC Membrane Phospholipids
Forms an impenetrable fluid barrier
Hydrophilic Polar Head Groups (Phosphatidyl-choline + Sphingomyelin)
arranged on membrane’s surface and oriented towards both the aqueous plasma and cytoplasm
Hydrophobic Nonpolar Acyl Tails (Phosphatidyl-serine + phosphatidyl-ethanol-amine)
sequestered/hidden from the aqueous plasma and cytoplasm to arrange themselves to form a central layer
Phosphatidyl-serine (PS)
The only negatively charged phospholipid that can redistribute to the outer layer of the RBC membrane and is responsible for apoptosis (splenic macrophages have receptors that bind to PS to destroy senescent and damaged RBCs)
Disruption of Phospholipid Distribution in RBC Membrane
Caused by sickle cell anemia and thalassemia (due to loss of phospholipid asymmetry “PS exposure”)
Phosphatidyl-inositol
Phospholipid that is present in both in both inner and outer layers of RBC membrane
Eryptosis
other term for RBC death
Factors that increase PS distribution to outer layer
CRP
Inflammatory conditions
Glycolipids
Sugar-bearing lipids that make up 5% of external half of RBC membrane; supports CARB side chains that extends to glycocalyx
Glycocalyx
Layer of CARBs that prevents microbial attack and protects RBCs from mechanical damage
Glycolipids.
Lipid portion of RBC membrane that carries carbohydrate-based blood group antigens (ABO and Lewis system).
Spectrins
Cytoskeletal proteins that form a hexagonal lattice, providing lateral or horizontal membrane stability
Transmembrane Proteins
Penetrates lipid bilayer and serve transport + adhesion sites and signaling receptors
Glycosylation
Through what process are glycolipids and transmembrane proteins joined together to make up the protective glycocalyx, supporting surface carbohydrates?
Cations that can’t permeate (are impermeable) into RBC membrane
Sodium (Na)
Potassium (K)
Calcium (Ca)
Anions that can permeate (are permeable) into RBC membrane
Bicarbonate (HCO3)
Chloride (Cl)
Cation Pumps
Consumes 15% of RBC ATP (ATP-dependent)
Sodium-ATPase: regulates Na intracellular-extracellular ratio (1:12)
Potassium-ATPase: regulates K intracellular-extracellular ratio (25:1)
Calcium-ATPase: extrudes/kicks out Ca to maintain low intracellular levels (5-10 umol per L)
Calmodulin
Cytoplasmic calcium-binding protein that controls Calcium-ATPase function
Aquaporin 1
Transmembrane protein that forms pores to create inward water flow (in response to internal osmotic changes)
Colloid Osmotic Hemolysis
Water enters RBC due to Na and Ca influx/accumulation, causing RBC to swell and eventually rupture (caused by ATP loss or pump damage)
“Where salt goes, water follows”
It’s why sodium and calcium have low intracellular-extracellular ratios
Senescence
Major way in which eryptosis occur; loss of glycolytic enzymes is central to this process of cellular aging
Extravascular Hemolysis
“Macrophage-mediated”
90% of Eryptosis
Senescent RBCs produce less ATP
Oxidation of RBC membrane
Disruption in cation pumps, increasing intracellular Na
Water enters RBC > Swelling
RBC loses flexibility and deformability > Discoid shape is lost > Spherocyte
Can’t pass through splenic sieve to exit spleen
Clinical Significance:
Increased unconjugated bilirubin leading
Increased urobilinogen + stercobilinogen (urine and fecal bilirubin breakdown products)
Ferritin
A protein-iron complex that is stored in the macrophage upon RBC lysis
Protoporphyrin
Component of heme in Hgb that is degraded into bilirubin
Globin
Component of Hgb that is degraded and returned to metabolic amino acid pool
Culling
Process of removing senescent RBCs
Intravascular Hemolysis
“Fragmentation Hemolysis”, “Mechanical Hemolysis”
10% of Eryptosis
Hemoglobin is broken down and released as free Hgb into the plasma
Haptoglobin: transports α- and β-dimers of Hgb into the liver (by hepatocytes)
Hemopexin: transports heme to liver (by LRP/CD91)
